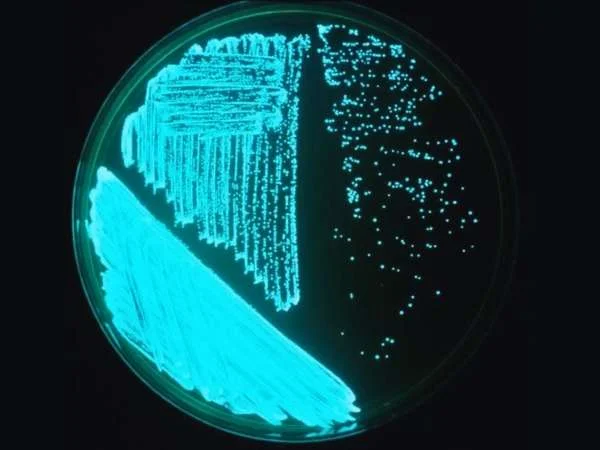
Chiết Xuất Lá Trầu Không: Giải Pháp Hiệu Quả Chống Vi Khuẩn Trên Tôm Thẻ

Hiện Tượng Tôm Tấp Mé Bờ và Cách Xử Lý:
Hiện tượng tôm tấp mé bờ thường là dấu hiệu của vấn đề trong ao nuôi, đặc biệt là liên quan đến chất lượng nước. Dưới đây là một số nguyên nhân và cách xử lý:
Nguyên Nhân Tôm Tấp Mé Bờ:
- Chất Lượng Nước Kém:
Nguyên Nhân: Nước có thể chứa nhiều chất cặn, khí độc như NH3, NO2, H2S, hoặc pH không ổn định.
Cách Xử Lý:
Đảm bảo cấp nước sạch từ nguồn đáng tin cậy.
Kiểm tra và điều chỉnh pH, giảm lượng chất cặn bằng cách sử dụng vi sinh vật hoặc các phương pháp lọc.
- Stress Tôm:
Nguyên Nhân: Tôm có thể bị stress do biến động nhanh về điều kiện môi trường, nước lạnh, hoặc áp lực đàn.
Cách Xử Lý:
Dùng các phương pháp giảm stress như tăng ánh sáng, giữ ổn định nhiệt độ, và hạn chế giao thông người xung quanh ao.
- Nguồn Nước Ô Nhiễm:
Nguyên Nhân: Nước đưa vào ao có thể chứa các chất ô nhiễm như hóa chất, vi khuẩn có hại.
Cách Xử Lý:
Kiểm tra nguồn nước trước khi cấp vào ao.
Sử dụng các phương pháp xử lý nước như tảo chùi, lọc.
Cách Xử Lý Tôm Tấp Mé Bờ:
- Kiểm Tra và Điều Chỉnh Thường Xuyên:
Hành Động: Kiểm tra định kỳ chất lượng nước, đặc biệt là nồng độ O2, pH, và khí độc. Điều chỉnh ngay khi phát hiện sự biến đổi.
- Sử Dụng Vi Sinh Vật Hữu Ích:
Hành Động: Thêm vi sinh vật có ích vào ao để cải thiện chất lượng nước và giảm tác động của chất cặn.
- Tăng Ánh Sáng:
Hành Động: Tăng cường ánh sáng trong ao có thể giúp giảm stress cho tôm và cải thiện tình trạng.
- Kiểm Tra Nguồn Nước:
Hành Động: Thực hiện kiểm tra chất lượng nước từ nguồn đưa vào ao. Lọc nước và xử lý trước khi cung cấp vào ao.
- Hạn Chế Giao Thông Người:
Hành Động: Giảm giao thông người xung quanh ao, giữ cho môi trường yên tĩnh hơn để giảm stress cho tôm.
- Điều Chỉnh Thức Ăn:
Hành Động: Điều chỉnh lượng thức ăn và chế độ dinh dưỡng phù hợp để giảm áp lực cho tôm.
- Kiểm Tra Sức Khỏe Tôm:
Hành Động: Thực hiện kiểm tra sức khỏe tôm, nếu cần, sử dụng các loại men vi sinh hỗ trợ tiêu hóa.
Lưu Ý Quan Trọng:
Luôn giữ kỹ thuật nuôi ao theo chuẩn, thường xuyên quan sát để phát hiện vấn đề sớm và có biện pháp xử lý kịp thời.
Nếu hiện tượng kéo đàn, tấp mé bờ kéo dài và không giảm đi sau khi thực hiện các biện pháp, nên tham khảo ý kiến chuyên gia nuôi tôm để đảm bảo an toàn cho đàn tôm.
Hi vọng những gợi ý trên sẽ giúp Bác Năm và bà con giải quyết tình trạng này một cách hiệu quả.